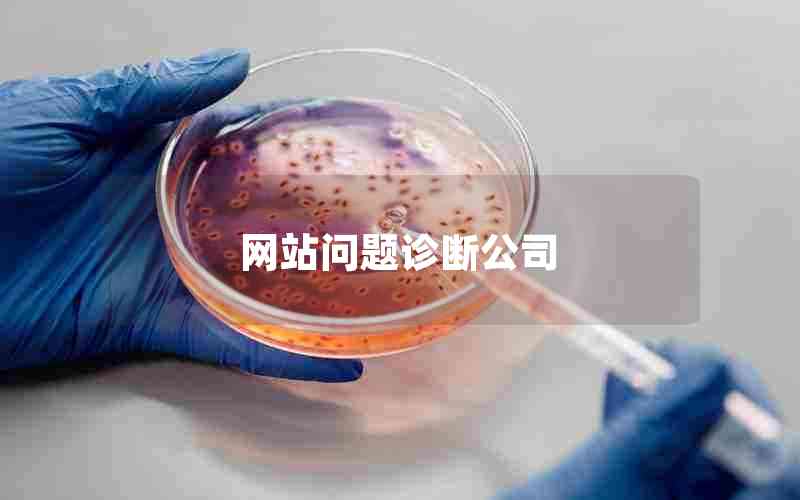

1、微信红包上线推广策略

近年来,微信红包已经成为了人们在生活中常用的支付方式之一。为了更好的推广微信红包,需要制定一些行之有效的推广策略。
要利用好微信社交平台的特点,通过组织微信群抢红包活动或者在微信朋友圈推送红包活动链接来吸引用户的注意力。这样的推广方式不仅能够快速扩散红包活动信息,还能引发用户的兴趣,增强用户参与度。
要抓住重点人群,对于那些在微信上经常进行转账支付的用户,通过向他们推送个性化的红包活动,让他们感受到微信红包支付的快捷便利。同时,也可以通过赞助热门直播或活动来增加红包的曝光度。
还要完善红包活动策略,比如可以根据用户的年龄、消费水平等分类推送红包活动,同时规定活动时间和红包金额范围,增加活动的趣味性和挑战性。
微信红包在支付领域已经具有了相当大的知名度和普及度,而通过制定好的推广策略,可以更好地将其推广至更多用户群体,让其在生活中发挥更大的作用。
2、微信红包限时推广是怎么回事

微信红包限时推广是指在微信中设置某个时间限制,让用户在规定时间内打开红包才能获取到红包中的金额。这种推广模式可以促进用户在短时间内高度关注、参与并分享,从而扩大品牌影响力。
微信红包限时推广最常见的形式是针对特定活动或节日进行的。例如,春节期间微信红包限时推广,用户可以在规定的时间里收到一定数量的微信红包,同时分享到朋友圈,增加品牌的曝光率和用户参与度。
此外,微信红包限时推广还可以用于境内外游戏竞技、线下活动等等。在游戏竞技活动中,微信红包作为奖励,增加用户对游戏的参与度;而在线下活动中,微信红包作为奖励,吸引更多用户参加。
微信红包限时推广是一种实用、有效的宣传方式。它可以在短时间内提高品牌知名度和用户参与度,增加产品销售额。对于企业来说,推广微信红包限时活动需要结合产品特点和目标市场来制定相应的策略,从而达到最好的效果。
3、微信上线红包功能

微信是一个备受欢迎的社交媒体平台,为了给用户们更好的交流体验,微信团队在2014年推出了红包功能。这项功能使得用户可以在微信上发送红包给朋友,家人以及同事。
微信红包功能的使用非常简单。只需要在微信聊天窗口中选择“红包”图标,然后在弹出的界面中设置红包金额和数量。一旦红包成功创建,就可以轻松分享给你的好友了。
当你被别人发送了一个红包,你就可以通过点击红包界面来领取红包。用户可以选择放弃领取或者领取红包的金额。红包功能的设计和操作都非常方便,使得用户在微信中发送或者领取红包变得轻松简单。
微信红包功能在中国普及开来后,也逐渐受到国外用户的欢迎。其简便的操作和快捷的资金转移,极大地方便了用户的交流和红包赠送。这也为微信在国际市场上的扩展提供了支持。
4、微信红包推广方案
随着移动互联网时代的到来,微信作为一款强大的社交软件,其用户数量以及使用频率也在不断地提升。为了进一步扩大微信的使用和推广,微信红包也渐渐成为了一种新的营销方式。
微信红包可以在传统的营销方式上进行创新,其操作简单、玩法多样,越来越受到企业和个人的喜爱。推广微信红包需要注意以下几个方面:
1. 设计创新:红包的设计需要与活动主题相匹配,并且要有吸引力,激发用户的参与欲望。
2. 策略合理:不同的活动需要采用不同的策略,比如定向、随机、分级等红包发放方式,以及搭配不同的活动规则,提高用户参与度和转化率。
3. 宣传推广:通过微信号、公众号、微信朋友圈等途径,将活动和红包宣传推广给目标用户、粉丝和朋友圈。
微信红包的使用不仅可以为企业带来品牌提升和用户增长,同时也可以提高用户的参与度和忠诚度,促进社交交流,为用户带来更多的快乐和福利。
Chatgpt 批量写原创文章软件下载地址:https://www.lol9.cn/chatgpt/8301.html
插件下载说明
未提供下载提取码的插件,都是站长辛苦开发,需收取费用!想免费获取辛苦开发插件的请绕道!
织梦二次开发QQ群
本站客服QQ号:3149518909(点击左边QQ号交流),群号(383578617)  如果您有任何织梦问题,请把问题发到群里,阁主将为您写解决教程!
如果您有任何织梦问题,请把问题发到群里,阁主将为您写解决教程!
转载请注明: 织梦模板 » 微信红包上线推广策略(微信红包限时推广是怎么回事)